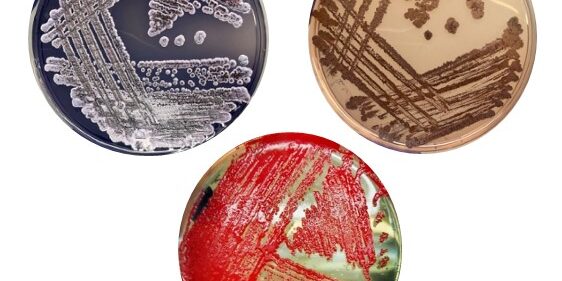
Microrganismi: alla scoperta del mondo invisibile

Microrganismi: alla scoperta del mondo invisibile
Tutto ciò che ci circonda è colonizzato da microrganismi: suolo, acqua, superfici, ma anche la nostra pelle ed il nostro corpo. I microrganismi sono gli organismi viventi più antichi e numerosi del pianeta, che non sono visibili ad occhio nudo a causa delle loro microscopiche dimensioni.
I microrganismi svolgono importantissimi ruoli ecologici e sono anche in grado di produrre molecole con proprietà di interesse farmacologico (es. antibiotici). In questa occasione, tramite l’utilizzo di microscopi ottici sarà possibile osservare alcuni microrganismi e valutare le loro differenze morfologiche e fisiologiche. Inoltre, sarà possibile osservare la crescita microbica ed apprezzare la pigmentazione di diversi batteri e microalghe (microorganismi fotosintetici) e delle molecole da loro prodotte. Saranno valutate le risposte dei diversi microrganismi a stress diversi, come sostanze antibatteriche, acqua ossigenata, sali e metalli. Attraverso la tecnica dello spooling sarà visualizzabile il DNA estratto dalle cellule
A cura di: Rosa Alduina, Alessandro Presentato, Valeria Villanova, Paola, Galluzzo, Fanny Claire Capri, Alessia Maria Sampino, Ylenia Di Leto, Annamaria Gallo, Clelia Ferraro.